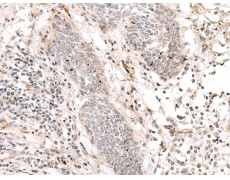
一抗

中文名稱: 兔抗NOTCH3多克隆抗體
英文名稱: Anti-NOTCH3 rabbit polyclonal antibody
別 名: CASIL, CADASIL
相關類別: 一抗
儲 存: 冷凍(-20℃)
宿 主: Rabbit
抗 原: NOTCH3
反應種屬: Human, Mouse, Rat
標 記 物: Unconjugate
克隆類型: rabbit polyclonal
技術規(guī)格
|
Background: |
This gene encodes the third discovered human homologue of the Drosophilia melanogaster type I membrane protein notch. In Drosophilia, notch interaction with its cell-bound ligands (delta, serrate) establishes an intercellular signalling pathway that plays a key role in neural development. Homologues of the notch-ligands have also been identified in human, but precise interactions between these ligands and the human notch homologues remains to be determined. Mutations in NOTCH3 have been identified as the underlying cause of cerebral autosomal dominant arteriopathy with subcortical infarcts and leukoencephalopathy (CADASIL). |
|
Applications: |
ELISA, WB, IHC |
|
Name of antibody: |
NOTCH3 |
|
Immunogen: |
Synthetic peptide of human NOTCH3 |
|
Full name: |
Notch 3 |
|
Synonyms: |
CASIL, CADASIL |
|
SwissProt: |
Q9UM47 |
|
ELISA Recommended dilution: |
1000-5000 |
|
IHC positive control: |
Human colon cancer |
|
IHC Recommend dilution: |
25-100 |
|
WB Predicted band size: |
244 kDa |
|
WB Positive control: |
Human colon cancer tissue |
|
WB Recommended dilution: |
200-1000 |



 購物車
購物車 幫助
幫助
 021-54845833/15800441009
021-54845833/15800441009